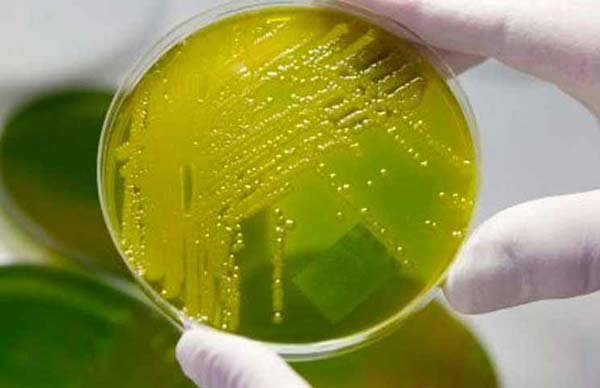
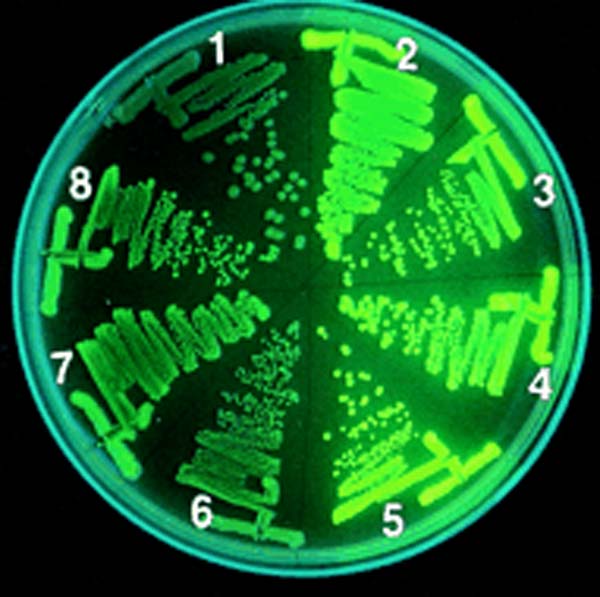

ল্যান্ডমাইন খোঁজার কাজটাকে অনেকটাই সহজ করে দিল এক ধরনের ব্যাকটেরিয়া। যারা ‘জোনাকি’র মতোই আলো ছড়াতে পারে অন্ধকারে। আর সেই আলো দিয়েই তারা দিতে পারে সিগন্যাল। জানাতে পারে, কোথায় মাটির নীচে গোপনে পোঁতা রয়েছে ল্যান্ডমাইন। ফলে, ল্যান্ডমাইন খোঁজার কাজটা করা যাবে এ বার অনেক বেশি নিরাপদেই।
রাষ্ট্রপুঞ্জের একটি রিপোর্ট বলছে, বিশ্বের ৭০টি দেশে কম করে ১০ কোটি ল্যান্ডমাইন পোঁতা রয়েছে এই মুহূর্তে। যার বিস্ফোরণে বছরে গড়ে জখম হন অন্তত ২০ হাজার মানুষ। রাজ্য পুলিশের এক পদস্থ কর্তার কথায়, ‘‘ল্যান্ডমাইন খোঁজা, তাদের নিষ্ক্রিয় করা আর সেগুলিকে নিরাপদে অন্যত্র সরিয়ে ফেলার কাজটা বেশ বিপজ্জনক। শ্রমিকও মেলে না সুলভে। কাজটা সময়সাপেক্ষও বটে।’’
সেই সমস্যা মেটাতেই গবেষণা এই শতাব্দীর গোড়ার দিকে শুরু হলেও নজরকাড়া আবিষ্কারটি হয়েছে একেবারে হালে। ইজরায়েলের জেরুজালেমের হিব্রু বিশ্ববিদ্যালয়ের গবেষকরা একটি বিশেষ ধরনের জেনেটিক্যালি মডিফায়েড ব্যাকটেরিয়া (জিএম ব্যাকটেরিয়া) বানিয়েছেন। যা মাটির নীচে কোথায় লুকোনো রয়েছে ল্যান্ডমাইন, তার ‘গন্ধ’ পেয়ে, ‘জোনাকি’র মতো জ্বলে উঠে নিজেরাই দিতে পারে সিগন্যাল। তার পর ঠিক কোন জায়গায় সেই ল্যান্ডমাইন পোঁতা রয়েছে, তা ধরা পড়ে যায় লেজার রশ্মির ‘মর্মভেদী নজর’-এ।
গবেষণাগারে সেই ফ্লুরোসেন্ট জিএম ব্যাকটেরিয়া
গবেষণাপত্রটি প্রকাশিত হয়েছে আন্তর্জাতিক বিজ্ঞান-জার্নাল ‘নেচার-বায়োটেকনোলজি’র সাম্প্রতিক সংখ্যায়।
গবেষণাগারে সেই ফ্লুরোসেন্ট জিএম ব্যাকটেরিয়া
অণুবীক্ষণের নীচে সেই ফ্লুরোসেন্ট জিএম ব্যাকটেরিয়া
ল্যান্ডমাইন খোঁজার বিপজ্জনক কাজটাকে কী ভাবে সহজ করে তুলছে ‘জোনাকি’ ব্যাকটেরিয়া?

পাতার নীচে মাটিতে পোঁতা ল্যান্ডমাইন, তাই জোনাকির মতো জ্বলে উঠেছে ওই ব্যাকটেরিয়া
ল্যান্ডমাইন বানানো হয় সাধারণত প্লাস্টিক বা কোনও পলিমার যৌগ দিয়ে। গবেষকরা দেখেছেন, ল্যান্ডমাইন থেকে এক ধরনের বাষ্প বা ভেপার বেরিয়ে আসে। যে বাষ্পের ‘গন্ধ’ পেয়েই ওই জিএম ব্যাকটেরিয়া জোনাকির মতো ফ্লুরোসেন্ট আলোর ঝলকানি দিতে শুরু করে। ল্যান্ডমাইন থেকে যত বেশি করে ওই বাষ্প বেরিয়ে আসে, ওই ব্যাকটেরিয়া ততটাই বেশি করে আলো ঝলকায়। আগে জানা ছিল, ওই ধরনের বাষ্পে কিছু গাছপালা রং বদলায়। সেই ‘সংকেত’ একটি লেজার ব্যবস্থায় ধরা পড়লে ওই লেজার রশ্মিই খুঁজে বের করতে পারে ল্যান্ডমাইনটিকে। ওই লেজার সিস্টেমটিকে কোনও গাড়ির ওপর, এমনকী ড্রোনেও বসিয়ে রাখা যায়।
মাটিতে পোঁতা রয়েছে মাইন, জোনাকির মতো জ্বলে উঠে সিগন্যাল দিচ্ছে ফ্লুরোসেন্ট ব্যাকটেরিয়া

তার মানে, ল্যান্ডমাইন খোঁজার কাজটা করা হবে আসলে দু’টি ধাপে। প্রথমে ‘জোনাকি’ ব্যাকটেরিয়ারা ল্যান্ডমাইন থেকে বেরিয়ে আসা বাষ্প বা ভেপারের ‘গন্ধ’ শুঁকে আলো জ্বালিয়ে সিগন্যাল দেবে, জানাবে- সেই এলাকায় মাটিতে পোঁতা রয়েছে কি না ল্যান্ডমাইন। তার পর সেই সিগন্যাল পেয়ে ঠিক কোন জায়গায় সেই ল্যান্ডমাইন পোঁতা রয়েছে, তা জানিয়ে দেবে লেজার রশ্মির ‘মাটি-ফোঁড়া চোখ’! সেকেন্ডে ১৮ সেন্টিমিটার গতিতে।
আরও পড়ুন- কোথা থেকে এল, কোথায় উধাও হয়ে গেল এই ‘ভিনগ্রহীদের আলো’?
বেল্কিন আর তাঁর সহযোগীরাই যে প্রথম ‘জোনাকি’ ব্যাকটেরিয়াদের নিয়ে ল্যান্ডমাইনের ‘গন্ধ’ শোঁকানোর কাজটা করেছেন, তা নয়। ২০০৯ সালে এই চেষ্টাটা প্রথম করেছিলেন এডিনবার্গ বিশ্ববিদ্যালয়ের গবেষকরা। কিন্তু নতুন প্রযুক্তি উদ্ভাবনের কাজটা প্রথম করলেন বেল্কিন আর তাঁর সহযোগী গবেষকরাই। তিন বছর আগে জেনেটিক্যালি মডিফায়েড এই ফ্লুরোসেন্ট ব্যাকটেরিয়া দিয়েই জলের মধ্যে জীবাণু বা দূষণ সৃষ্টিকারী কণা ও পদার্থ খুঁজে বের করার প্রযুক্তি উদ্ভাবন করেছিলেন বেল্কিন ও তাঁর সহযোগীরা।
এই পদ্ধতিকে কী ভাবে আরও উন্নত করা যায়?
ল্যান্ডমাইন

আনন্দবাজারের পাঠানো প্রশ্নের জবাবে তেল আভিভ থেকে মূল গবেষক, হিব্রু বিশ্ববিদ্যালয়ের বায়োটেকনোলজি বিভাগের অধ্যাপক শিমশন বেল্কিন ও তাঁর ভারতীয় সহযোগী গবেষক রমেশ ভেঙ্কটেশ লিখেছেন, ‘‘এক, ফ্লুরোসেন্ট জিএম ব্যাকটেরিয়াগুলির স্পর্শকাতরতা (সেনসিটিভিটি) আরও বাড়াতে হবে। যাতে চট করেই তারা ল্যান্ডমাইন থেকে বেরিয়ে আসা বাষ্পের ‘গন্ধ’ পেয়ে যায়। দুই, ওই ব্যাকটেরিয়াগুলিকে যাতে বিভিন্ন এলাকার বিভিন্ন রকম তাপমাত্রায় অনেক ক্ষণ বাঁচিয়ে রাখা যায়। তিন, পৃথিবীর সব প্রান্তের সব রকম তাপমাত্রাতেই যেন সেগুলিকে সমান সক্রিয় রাখা যায়।’’
আর কী ভাবে এই প্রযুক্তির উন্নতি ঘটানো সম্ভব?
বিশেষজ্ঞদের বক্তব্য, এ ছাড়াও এই প্রযুক্তির আরও দু’-একটি দিককে উন্নত করে তোলার প্রয়োজন রয়েছে।
ফ্লুরোসেন্ট ব্যাকটেরিয়া আর লেজার রশ্মি দিয়ে যে ভাবে খুঁজে বের করা হয়েছে মাইন পুঁতে রাখার জায়গাগুলি

এক, লেজার রশ্মি যে গতিতে তার ‘মাটি ফোঁড়া চোখ’ দিয়ে এখন ল্যান্ডমাইন খুঁজে বের করতে পারছে, সেই গতিটাকে আরও অনেকটা বাড়ানোর প্রয়োজন রয়েছে। না হলে, খুঁজে বের করার আগেই ল্যান্ডমাইন ফেটে গিয়ে বিস্ফোরণ ঘটিয়ে ফেলতে পারে।
দুই, ওই লেজার রশ্মি যাতে মাটির নীচে আরও বড় এলাকায় ও আরও বেশি গভীরে ল্যান্ডমাইন খুঁজে বের করার কাজটা করতে পারে, তার জন্যেও প্রযুক্তিটাকে উন্নত করতে হবে গবেষকদের।
ছবি সৌজন্যে: শিমশন বেল্কিন, হিব্রু বিশ্ববিদ্যালয়, ইজরায়েল









